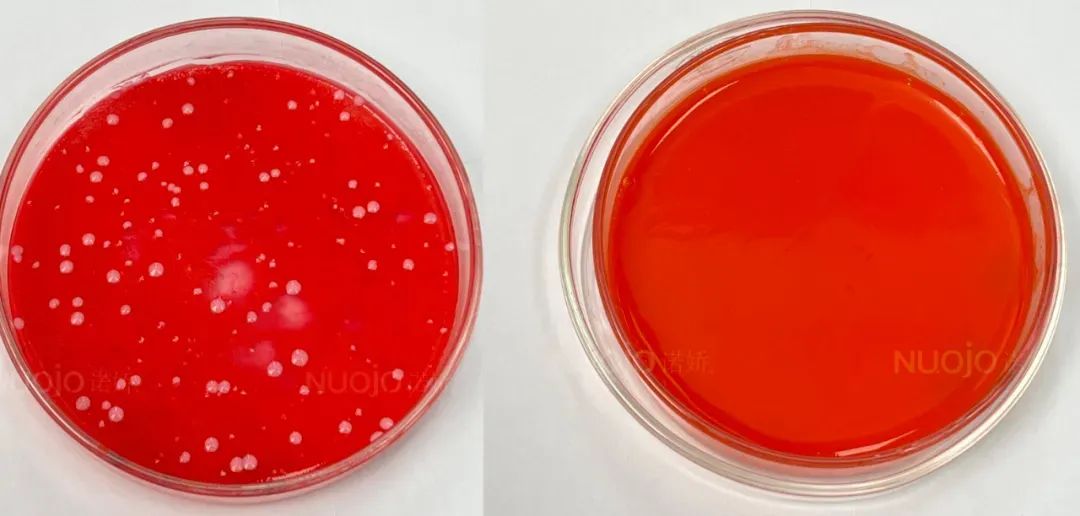

改乌唇实战指南 | ResAP欧盟安全色料,逆袭乌暗唇色
FAMISOO法米索
2025-03-28


90%的暗沉源于这三大“元凶”
色料沉积、深度失控、体质差异
乌唇矫正=安全代谢底色+科学色彩重建
ResAP欧盟安全色料从源头阻断二次色沉
▼
法米索按不同程度的乌唇
应用ResAP欧盟安全色料橘红调色系
讲解下分阶改色方案,一起来来学习下
01 轻度乌唇(唇周微暗/无增生)
核心策略
暖橘中和冷青,提亮底色
无需担心肤色差异,橘调还可提亮显白
▽▽▽
转色层:【橙红】薄敷打底(中和青黑素)
目标色:【胭脂红】叠加晕染(模拟原生气色)
仪器搭配:法米索「全能王者」战神多频仪+0.35mm单针
(回弹技术精准控深0.2mm)
02中度乌唇(全唇泛灰/局部色斑)
核心策略
双阶转色,重建唇部好底色
超微粒纳米级色分子,足够细腻易上色
▽▽▽
第一层:【万用色】破界转色(分解淤积色素)
第二层:【胭脂红+橙红+珍珠白2:1:1】渐变塑形(注入鲜活感)
03重度乌唇(紫黑淤积/乌暗无光)
核心策略
双阶调色,加大配比
浅色减低乌暗,匹配橘调提亮显白
▽▽▽
第一层:【万用色+珍珠白2:1】破界转色(分解淤积色素)
第二层:【樱桃红+橙红+珍珠白2:1:1】渐变塑形(注入鲜活感)

为什么ResAP欧盟色料是
改乌唇的“终极解药”??
产品安全壁垒
通过ResAP欧盟永久性化妆品认证
大货全检微生物、重金属不超标
▼
左是别家纹绣色料,右是ResAP欧盟安全色料
作品效果精美
超微粒纳米级粉色分子
(粒径<0.02μm)
极致细腻,贴合肌肤纹理,更好上色留色
▼

测试结果保障
PSGC-COLOR专利锁色配方
颜色艳丽持久留色
所见即所得,不轻易反灰分层
▼
法米索助力1000+家纹绣机构
实现矫正问题眉眼唇培训
为合作伙伴铺设
从技术赋能到商业增值的最短路径
让每一次的合作,都成为双向创收的起点
阅读241